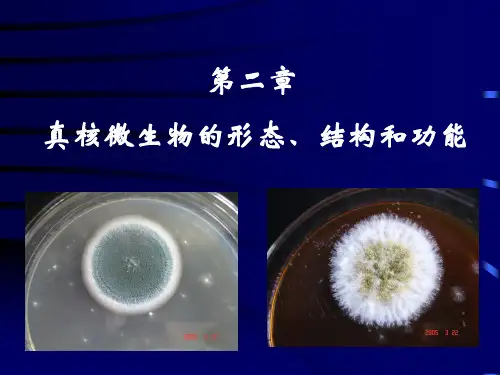

真核微生物的形态与结构
- 格式:ppt
- 大小:2.25 MB
- 文档页数:36

第二章真核微生物的形态与结构名词解释:01.节孢子:一些真菌在进行无性繁殖时,其菌丝顶端停止生长后,产生许多横隔膜,这些隔膜处断裂开后便形成一节一节的细胞,这些节状细胞即为节孢子。
02.厚垣孢子:一些真菌在不良的环境条件下,细胞原生质收缩变成近圆形,外生一层厚壁结构,当环境条件适宜时,它可以萌发重新长出菌丝。
03.分生孢子:一些真菌在进行无性繁殖时,在菌丝分枝顶端的产孢细胞(或分生孢子梗)上分割或缢缩而形成的单个或成串的孢子。
04.孢囊孢子:某些真菌(如根霉)在进行无性繁殖时,产生在孢子囊内不具有鞭毛,不能游动的一种内生无性孢子。
06.子囊孢子:子囊菌亚门的真菌产生于子囊中经减数分裂后形成的有性孢子。
07.接合孢子:由两种不同遗传性的菌丝分别长出形状相同或略有不同的配子囊接合后发育而成的有性孢子。
08.无性繁殖:不经过两性细胞的配合,由营养体细胞的分裂或营养体菌丝的分化而形成同种新个体的过程。
09.无性孢子:未经性细胞(核)结合,直接在营养体上产生的孢子。
10.菌丝:丝状真菌的结构单元,是一条具有分枝的管形丝状体,外由细胞璧包被,里面充满原生质和细胞核。
幼时无色,老后常呈各种不同的颜色。
11.匍匐枝(匍匐菌丝):毛霉目的一些真菌,在基质上形成一种节段的跳跃菌丝。
12.异宗配合:某些真菌必须由不同交配型的菌丝相结合才能产生有性生殖的性亲和方式。
13.同宗配合:某些真菌,其有性生殖发生在同一个菌体中,是一种自身可孕的结合方式。
14.菌核:一些真菌的菌丝,紧密聚集交织成一种坚硬的,具有抗逆功能的休眠体,外壁由深色厚壁细胞组成,内层由浅色拟薄壁细胞组成。
当条件适合时,可萌发出菌丝或产生子实体。
15.假根:在毛霉目中,一些真菌在匍匐菌丝上或在两匍匐菌丝交连下方生长出须根状菌丝,它们深入基质中吸收营养并支持上部的菌体,这种须根状菌丝称为假根。
16.孢子囊:一些真菌进行无性繁殖时,在菌丝分枝的顶端形成膨大的囊状结构体,其中原生质经分割后形成内生的无性孢子。



真核微生物的形态、构造和功能的学习小结一、真核微生物的概述1.概念:是一大类细胞具有核膜,能进行有丝割裂,细胞质中存在线粒体或同时存在叶绿体等多种细胞器的生物。
2.真核微生物的要紧类群:3.真核微生物的大体特征真核微生物包括真菌、藻类和原生动物有明显的核。
核有核膜将其与细胞质分开所有真菌都是有机营养型,藻类为无机营养型的光合生物真菌细胞都有细胞壁,细胞壁成份多数以几丁质为为主,部份低等真菌细胞壁成份以纤维素为主,(原生动物无细胞壁,真菌多数为分枝丝状即霉菌,少数为单细胞如酵母)二、真菌真菌是最重要的真核微生物,故是本章重点,而依照真菌外观特点可粗分为酵母菌、霉菌和蕈菌3类,下面为三种菌类的简单总结酵母菌酵母菌是一个通俗名称,一样泛指能发酵糖类的各类单细胞真菌,酵母菌有以下5个特点:a)个体一样以单细胞状态存在b)多数营出牙繁衍c)能发酵糖类产能d)细胞壁常含甘露聚糖e)常生活在含糖量较高、酸度较大的水生环境中(一)酵母菌的形态大小形态:卵圆形、球形、柠檬形、香肠状、菌丝状大小:~10ⅹ~21μm(二)酵母菌菌落特点酵母菌菌落与细菌菌落相似,但大而厚,呈油脂状或蜡脂状,表面滑腻、湿润、乳白色或红色。
培育时刻长时菌落表面发生皱折有酒香味。
(三)酵母菌的繁衍一、无性繁衍:芽殖、裂殖二、有性繁衍:子囊孢子霉菌(一)霉菌的形态一、霉菌的菌丝和菌丝体菌丝:是指由细胞壁包被的一种长管状,有分枝的细丝结构。
一样宽度达5~10微米。
菌丝体:有分枝的菌丝彼此交织而形成的结构。
二、营养菌丝体的分类营养菌丝体气生菌丝体(二)霉菌菌落概念:在自然基质或人工培育基上由一段或一丛菌丝、或一个孢子或一堆孢子进展而成的菌丝整体(三)霉菌的繁衍一、无性繁衍1)菌丝片段产生新个体2)产生无性孢子:节孢子厚垣孢子孢囊孢子分生孢子游动孢子二、有性繁衍:卵孢子接合孢子子囊孢子担孢子四、工业上常见的霉菌毛霉、根霉、曲霉、青霉三、原核生物与真核生物的区别比较项目原核生物真核生物核无真核,拟核,没有核膜,没有核仁,只有一条DNA 真核,有核膜,有核仁,有一至多条DNA细胞分裂二分裂有丝分裂,减数分裂繁殖方式有无性繁殖,通常没有有性繁殖方式有无性繁殖及有性繁殖方式细胞器有间体无细胞器:无线粒体、高尔基体、内质网、叶绿体、中心体无间体、有细胞器:线粒体、高尔基体、内质网、叶绿体、中心体。

第二章真核微生物的形态构造和功能真核微生物(eukaryotic micro-organisms):是一大类细胞核具有核膜,能进行有丝分裂,细胞质中存在线粒体或同时存在叶绿体等多种细胞器的微生物。
真菌、显微藻类和原生动物等是属于真核微生物。
我们的重点是真菌,真菌包括酵母、霉菌和蕈菌。
真核生物与原核生物的比较:第一节酵母菌(Yeast)酵母菌:泛指能发酵糖类的各种单细胞的真菌。
5个特点:(1)个体一般以单细胞状态存在(2)多数营出芽繁殖(3)能发酵糖类产能(4)细胞壁常含甘露聚糖(5)常生活在含糖量较高、酸度较大的水生环境中一、分布及与人类的关系1. 多分布在含糖的偏酸性环境,也称为“糖菌”如水果、蔬菜、叶子、树皮等处,及葡萄园和果园土壤中等。
有的酵母菌可利用烃类物质如:假丝酵母、毕赤式酵母是正烷烃发酵生产二羧酸的高产微生物。
为石油化工开发出许多崭新的工艺过程和生产出许多用化学合成所不能生产的新产品。
2. 重要的微生物资源酵母菌是人类的第一种“家养微生物”酿造工业:酒类的生产、果汁发酵食品工业:面包、馒头的制作医药工业:核苷酸、CoA、细胞色素C、凝血质和维生素等生化药物和试剂饲料工业:单细胞蛋白(SCP)---“人造肉”化学工业:有机酸、酒精、脂肪酸和甘油等3. 重要的科研模式微生物啤酒酵母(Saccharomyces cerevisae)第一个完成全基因组序列测定的真核生物(1996)表达外源蛋白功能的优良“工程菌”---真核微生物4. 有些酵母菌具有危害性有些酵母菌能引起皮肤、呼吸道、消化道、泌尿生殖道疾病。
白假丝酵母(Candida albicans)白色念珠菌新型隐球菌(Cryptococcus neoformans)引起鹅口疮、阴道炎或肺炎等疾病二、酵母菌的形态和大小酵母菌细胞的形态通常有球形、卵圆形、圆柱、梨形、腊肠形、椭圆形、柠檬形或藕节形等。
其细胞直径一般是细菌的10倍左右。
酵母菌无鞭毛,不能游动。

第二章真核微生物的形态、构造和功能一、名词解释1.真核微生物:即细胞核具有核膜,能进行有丝分裂,细胞质中存在线粒体或同时存在叶绿体等细胞器的微小生物,包括真菌、显微藻类和原生动物等。
2.真菌:具有细胞壁,不含叶绿素,异养型并进行吸收营养,菌丝呈分枝的丝状和以孢子进行繁殖的单细胞或多细胞真核生物。
3.酵母菌:泛指能发酵糖类的各种单细胞真菌。
4.霉菌:是丝状真菌的俗称,通常指菌丝体较发达又不产生大型肉质子实体结构的真菌。
5.蕈菌:又称伞菌,通常指能形成大型肉质子实体的真菌,包括大多数的担子菌类和极少数的子囊菌类。
6.“9+2”型鞭毛:即真核微生物的鞭毛,外圈9组二联微管,内包有一对中央微管的结构。
7.细胞核:是细胞用以控制其一切生命活动的遗传信息(DNA)的储存、复制和转录的主要部位,它以染色质为载体储存了细胞内绝大部分的遗传信息。
8.核糖体:是存在于一切细胞中的少数无膜包裹的颗粒状细胞器,具有蛋白质合成功能,由40%蛋白质和60%RNA共价结合而成。
9.假菌丝:酵母菌进行出芽生殖时,子母细胞不立即分离而以狭小的面积相连,则称这种藕节状的细胞串为假菌丝。
真菌丝:酵母菌进行出芽生殖时,子母细胞相连,且其间的横隔面积与细胞直径一致,则称这种竹节状的细胞串为真菌丝。
10.吸器:是一种只在宿主细胞间隙间蔓延的营养菌丝上分化出来的短枝,它可在侵入细胞内形成指状、球状或丝状的构造,用以吸取宿主细胞内的养料而不使其致死。
11.菌核:是一种形状、大小不一的休眠菌丝组织,在不良外界条件下,可保存数年生命力。
12.子实体:是指在其里面或上面可产生无性或有性孢子,有一定形状和构造的任何菌丝体组织。
13.孢子囊:一些真菌进行无性繁殖时,在菌丝分枝的顶端形成膨大的囊状结构体,其中原生质经分割后形成内生的无性孢子。
14.分生孢子:一些真菌在进行无性繁殖时,在菌丝分枝顶端的产孢细胞(或分生孢子梗)上分割或缢缩而形成的单个或成串的孢子。

第二章真核微生物的形态与结构名词解释01.节孢子:02.厚垣孢子:03.分生孢子:04.孢囊孢子:06.子囊孢子:07.接合孢子:08.无性繁殖:09.无性孢子:10.菌丝:11.匍匐枝(匍匐菌丝):12.异宗配合:13.同宗配合:14.菌核:15.假根:16.孢子囊:17.真菌:18.菌丝体:19.吸器:20.初生菌丝:21.次生菌丝:22.囊轴:23.菌褶:24.真菌子实体:25.担孢子:26.卵孢子:28.锁状联合:29.半知菌:30.闭囊壳:31.子囊壳:32.子囊盘:33.子囊果:34.担子果:35.核配:36.质配:39.子座:40.鞭毛菌:41.配子:44.真菌生活史:是非题11.产生在子囊内的孢子叫孢囊孢子,内生。
(答案)12.真菌菌丝的宽和长用nm表示。
(答案)13.真菌菌丝的宽和长通常用μ、m表示。
(答案)14.毛霉菌进行有性生殖时,产生的有性孢子叫孢囊孢子。
(答案)15.根霉菌的无性繁殖产生分生孢子,有性生殖产生接合孢子。
(答案)16.毛霉菌的无性繁殖产生孢囊孢子,有性生殖产生卵孢子。
(答案)17.青霉菌根据分生孢子梗的排列可分为两类,即一轮青霉和多轮青霉。
(答案)18.青霉菌根据分生孢子梗的排列可分为三组,即一轮青霉,二轮青霉和多轮青霉。
(答案)19.在多轮青霉中,小梗是着生在梗基上。
(答案)20.在多轮青霉中,小梗是着生在附枝上。
(答案)22.真核微生物细胞中的线粒体是能量代谢的细胞器。
(答案)23.Mucor和Rhizopus的绝大多数有性生殖靠异宗配合形成接合孢子。
(答案)24.Mucor和Rhizopus所形成的孢囊孢子无鞭毛,不能游动,通常为圆形。
(答案)25.真菌的每一段菌丝都可以发展成为一个新的菌体。
(答案)26.生产酱油是利用米曲霉产生的蛋白酶。
(答案)27.酵母菌进行有性生殖时产生的有性孢子是孢囊孢子。
(答案)28.毛霉菌是一种子囊菌,可作为糖化菌应用于酿造工业中。


微⽣物第⼆章真核微⽣物的形态第⼆章真核微⽣物的形态、构造和功能习题⼀、名词解释。
半知菌:是⼀群只有⽆性阶段或有性阶段未发现的真菌。
孢囊孢⼦:孢⼦囊中继核融合和有丝分裂之后在分裂过程中形成的孢⼦。
孢⼦囊:是植物或真菌制造并容纳孢⼦的组织。
闭囊壳:是⼦囊菌门、不整囊菌纲的⼦囊果(产⽣⼦囊孢⼦的结构),呈球形,⽆孔⼝的封闭状。
膜边体:是⼀种位于菌丝细胞四周的质膜与细胞壁间、由单层膜包裹的细胞器。
初⽣菌丝:是担⼦菌中由担孢⼦发芽所⽣的单倍体(n)菌丝。
蒂痕:在⼦细胞上相应地留下的⼀个痕迹。
分⽣孢⼦:常指由真菌产⽣的⼀种形⼩、量⼤、外⽣的⽆性繁殖体。
厚垣孢⼦:各类真菌均可形成的⽆性孢⼦,由断裂⽅式产⽣,壁厚,寿命长,能抗御不良外界环境。
⼏丁质酶体:⼀种活跃于各种真菌菌丝体顶端细胞中的微⼩泡囊。
假根:有些真菌的菌丝体长出的根状结构,具有吸取养和固着菌体的作⽤。
假酵母:只进⾏⽆性繁殖的酵母菌。
假菌丝:当进⾏芽殖后,长⼤的⼦细胞与母细胞不马上分离,以狭⼩的⾯积连接,形成藕节状的细胞全,称为假菌丝。
酵母菌:酵母菌范指能发酵的各种单细胞真菌。
接合孢⼦:两个形态相似的配⼦或菌丝体融合产⽣的合⼦。
节孢⼦:菌丝依靠隔膜裂断⽽产⽣的孢⼦菌核:是⼀种形状、⼤⼩不⼀的休眠菌丝组织。
菌丝:霉菌营养体的基本单位。
菌丝变态:为适应不同的环境条件和更有效的摄取营养满⾜⽣长发育的需要,许多霉菌的菌丝可以分化成⼀些特殊的形态和组织,这种特化的形态称为菌丝变态菌丝球:在机械搅拌罐中,霉菌或放线菌的菌丝体有时会缠绕在⼀起,形成紧密的⼩球,俗称菌丝球。
菌丝体:许多菌丝相互交织形成的菌丝集团称为菌丝体。
菌物:是菌类的⼀种,包括真菌、黏菌、卵菌和丝壶菌,它们在形态、营养⽅式与⽣态上有许多相似之处,从⽽构成了⼀个关系⼗分密切的⽣物类群。
菌褶:指担⼦菌类伞菌⼦实体(担⼦果)地菌盖内侧地皱褶部分,或由菌褶原发育成的结构。
霉菌:菌丝体较发达⼜不产⽣⼤型⾁质⼦实体结构的真菌。